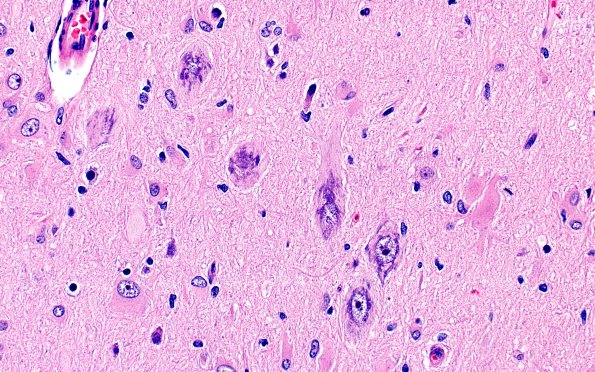
17B5 Tuber (Gene defect, Case 17) H&E 40X 1

Table of Contents
Washington University Experience | DEVELOPMENTAL MALFORMATIONS | Tuberous Sclerosis | 17B5 Tuber (Gene defect, Case 17) H&E 40X 1
Neurons are enlarged and dysmorphic and, in many cases, located superficially in the cortex. (H&E)